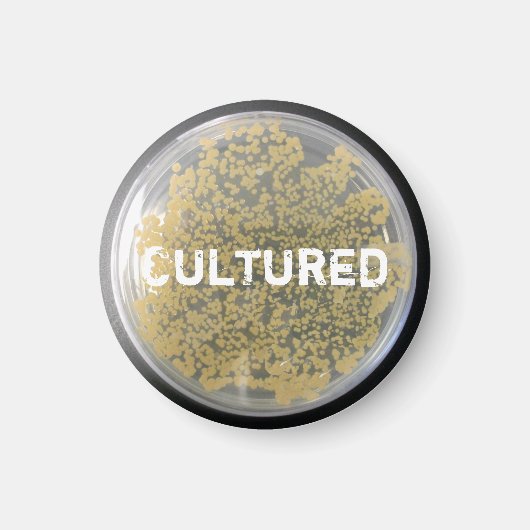
"Cultured Bacteria Culture Plate Magnet (Vorne)

Sale Preis 3,87 €.
Originalpreis 4,55 € pro Magnet
Du sparst 15%
"Cultured Bacteria Culture Plate Magnet
Produkt-Details anzeigenÜber Magnete
Verkauft von
Über dieses Design
"Cultured Bacteria Culture Plate Magnet
Foto einer Bakterienkulturplatte mit Bakterienkolonien. Anpassbarer Text, "Kultuered", in der Mitte gedruckt.
Automatische Übersetzung
Kundenrezensionen
4.7 von 5 Sternen Bewertung96 Bewertungen insgesamt
96 Bewertungen
Bewertungen für ähnliche Produkte
5 von 5 Sternen Bewertung
Von Christina M.19. April 2021 • Geprüfter Kauf
Magnet, Design: Kreis, Größe: Standardgröße, 5,7 cm
Bewertungsprogramm bei Zazzle
Wir haben an unsere Belegschaft und Mieterschaft Klimt-Magnete verschenkt, als Osterüberraschung. Alle haben sich sehr gefreut. Die Magnete sehen wunderschön aus und liegen fest am Untergrund an. Sie halten das Versprechen, also in Funktion und Optik. Der Kundendienst war hervorragend. Schöne, klare Farben, sie wirken sehr frisch
5 von 5 Sternen Bewertung
Von Thomas S.6. Juli 2024 • Geprüfter Kauf
Magnet, Design: Kreis, Größe: Standardgröße, 5,7 cm
Auch hier wurde Alles super umgesetzt Danke erneut, denn hier habe ich schon öfters bestellt. Danke! Der war einwandfrei, denn Alles hat gestimmt.
5 von 5 Sternen Bewertung
Von Nancy B.25. November 2021 • Geprüfter Kauf
Magnet, Design: Kreis, Größe: Klein, 3,2 cm
Bewertungsprogramm bei Zazzle
Klein, aber fein. Als Urlaubserinnerung eine super Sache, die wenig Platz in Anspruch nimmt 😉 wobei ich das nächste Mal allerdings vielleicht doch eine Nummer größer wählen werde. Das einzige was mir nicht so gefiel, war die sehr lange Lieferzeit. Hatte es Ende Oktober bestellt und am 24.11., also fast 1 Monat später erst erhalten. Aber das warten hat dich gelohnt 😉. Bildqualität war auch super 👍
Tags
Andere Informationen
Produkt ID: 147473830455350110
Gemacht am: 1.5.2013, 15:49
Bewertung: G
Zuletzt angesehene Produkte



